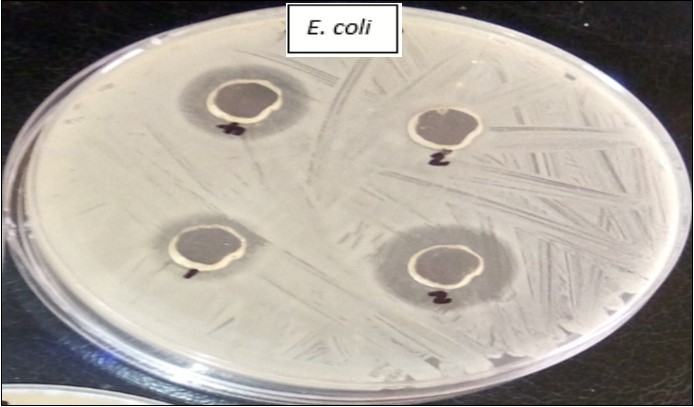
Zones of inhibition of the extracts on Escherichia coli (hole 3 with distiled water as control shows no zone of inhibition)

Investigation of Antimicrobial Activity of the Extracts of the Leaves, Stembark and Root of Allanblackia floribunda: An Alternative Paradigm Shift Outcome.
Abstract
Over the years, plants have been a major source of medicines, especially in the rural areas of the developing communities, with probably lack of functional health care facilities and trained health care personnel on hand for emergency medical response. However, with the dynamics and improvement in science and medicine, chemically synthesized drugs were being introduced and used to treat myriad of critical illnesses across board. Nonetheless, these were further strengthened owing to the increasing trend of drug resistance outcome, especially by the emerging and re-emerging infectious microorganisms. Thus, in the light of the above, there is a gradual but increasing steady return to the use of plants as sources of medicine and treatment of antibiotic resistance pathogens and illness across the globe. This study therefore, explores the use of antimicrobial activity of the leaves, stembark and root of Allanblackia floribunda on four bacterial isolates namely Staphylococcus aureus, Escherichia coli, Pseudomonas sp. and Bacillus sp. Methylated spirit, ethanol and distilled water were used as the extraction solvents differently. Ethanol extracts proved to be a better solvent compared with the other two while the extracts from distilled water were not active against any of the isolates. However, all the three ethanol extracts were more active against S. aureus while Pseudomonas sp. showed a higher level of resistance to the extracts. The leaves and root of the plant were more active on most of the isolates compared with the stembark as shown in the results section.
Author Contributions
Academic Editor: Yu Cao, H. Lee Moffitt Cancer Center & Research Institute, United States.
Checked for plagiarism: Yes
Review by: Single-blind
Copyright © 2019 Azuonwu Obioma, et al.
This is an open-access article distributed under the terms of the Creative Commons Attribution License, which permits unrestricted use, distribution, and reproduction in any medium, provided the original author and source are credited.
Competing interests
The authors have declared that no competing interests exist.
Citation:
Introduction
The use of plants as a source of drugs has for a long time been recognized and appreciated, thus has resulted in the discovery of plants with the tendency of strong potency to cure illnesses 1. Nonetheless, WHO survey report show that about 80% of persons living in developing countries depend on traditional medicines; most of which are obtained from plants 2. Nevertheless, in Africa specifically, interests in plant exploration as source of medicine have increased geometrically, over the recent years when compared with the past or dark ages. This interest stems from the fact that microorganisms are developing resistance to most drugs, as such most of the cheap and broad-spectrum antimicrobial drugs have become less, or non-effective against a good number of fastidious and emerging pathogens of medical importance. Nevertheless, the ineffectiveness of these drugs could probably stem from the frequent use of drugs by self-medication, consumption of under dose or overdose, as well as the acquisition of resistant genes by these microorganisms probably, through their frequent contact and interaction with the contaminated environment, even as the increasing upsurge of climate change variation index, cannot be left out as one of the seemingly promoter of high prevalence cases of antibiotic resistance issues across the globe. Sadly, this has become a public health issue, and so the need to explore alternatives approach for the treatment of infections and diseases cannot be over emphasized at this point. Studies on plants have continued to grow from strength to strength, as most of the drugs obtained from plants are secondary metabolites which are not necessarily needed by plants but however needed by humans as potent therapeutic substances 3.
In recent times, some plants and fungi have been found to also have antioxidant activity, not just antimicrobial activity alone. These antioxidants and antimicrobials are useful in food industries as natural additives, thus replacing the synthetic (chemically synthesized) antioxidants and antimicrobials 4. An example is that from the mushroom Pleurotuspulmonarius and Pleurotusostreatuswhich demonstrated promising antimicrobial activity against some pathogenic microorganisms 5. Nevertheless, these discoveries have thus, created a huge milestone of achievement in the invention of new effective drugs, due to their relatively low cost and less side effects in practical terms of application 6.
In Western Africa, medicinal plants have been used severally in the treatment of bacterial and fungal infections 7. In Nigeria, especially in the rural areas, most families rely on the different parts of bitter leaf, scent leaf and sour sop not only as spices or in cooking but also in the treatment of different illnesses such as gastroenteritis and fever. Spices and herbs have been useful in treating pathological infections 8. Wounds and chronic skin ulcers have been treated using herbs prepared locally and other substances that occur naturally in the environment for many years now 9; even in the failure of antibiotics, these plants and herbs have proved to be effective 10. Plants such as Vernonia amygdalina(bitter leaf) has been studied and found to be able to inhibit the growth of Staphylococcus aureus, Escherichia coli, Pseudomonas aeruginosa, Klebsiella pneumoniae and Candida albicans 11 respectively.
The Allanblackiagenus is of the Guttiferae family and Clusiodeae subfamily. It is found in Congo, Nigeria, Ghana, Cameroon, Tanzania, Angola and Sierra Leone 12. The seeds from the trees are used in preparing food, soap and cooking oil. Its oil has a higher melting point and is able to congeal even when the cooked food is consumed. Although it is native to the wild, in recent times, it has been domesticated due to the high demand of its oil which serves as a means of income for farmers in Africa. This is because the renowned Unilever Company has found out that the oil from this plant is useful in the production of ice creams, spreads and vegetable-based dairy products. The oil is highly nutritive and needed by cosmetic industries as source of raw materials 12, 13.
Furthermore, both the seeds and fruits are edible; its bitter seedcake is used as animal feed, while vegetable oil is produced from its seeds. During the First World War, the seeds were majorly used as a substitute for butter and in chocolate production. The bark is pounded and used as toothache pain reliever and in the treatment of diarrhoea in Ghana. Its generic name was named after Allan Black who was a 19th century Kew botanist while the specific name floribunda explains the abundant flowers this species has 14.
However, in the extraction of active substances from plants, the choice of solvent has been found to determine the efficacy of the extract. Ethanol is most often used for extraction and in some cases methanol; nevertheless, both are usually more effective when compared with the use of water (distilled water) as an extraction solvent. The method of extraction also differs as methods such as maceration, Soxhlet, Supercritical Fluid Extraction (SFE), Ultrasound Assisted Extraction (UAE) and Microwave Assisted Extraction (MAE) may be used in the extraction of bioactive substances from plants. This study was thus aimed at determining the effectiveness of extracts of different parts of Allanblackia floribunda on some pathogenic microorganisms. It is therefore strongly believed that this investigation would provide a robust data on the parts of the plant which are endowed with the large amount of deposition of the therapeutic substances, as well as elucidate the best and effective solvent medium for the extraction of the antimicrobial component of the plant parts. It is finally our firm expectation that the information generated from the study, would certainly promote the use of medicinal plant extract for treatment of infections among the weak and vulnerable subjects in the developing communities, especially in the era of multi-drug resistance circumstances and high cost of broad spectrum antibiotics with high index of efficacy, even as these has remains a massive challenge towards solving health problems, especially in remote villages of developing nations
Methodology
Sample Collection
The mature plant Allanblackia floribunda used in this study was obtained from Mgbere village, Ibaa Community in Emohua Local Government Area of Rivers State. This is one of the remote communities in Rivers State and the occupations of the inhabitants of the community are fishing, farming and petty trading. Furthermore, the plant was identified by a plant taxonomist in the Biological Science Department of Rivers State University.
The test microorganisms used were obtained from the Microbiology unit of the University of Port Teaching Hospital in Port Harcourt, they were sub-cultured and thereafter sustained in nutrient broth prior to use. The organisms used were Escherichia coli, Staphylococcus aureus, Bacillus sp. and Pseudomonas sp. Gram’s test and some biochemical tests such as coagulase, catalase, sugar fermentation, urease, motility and citrate were carried out to confirm and validate the identity of the collected isolates as described by Cheesbrough 15
Extraction Process
Ethanol and methylated spirit were used as extraction solvents while distilled water was used as a control extraction solvent and the maceration method was used also. The plant parts (leaves, stembark and roots) to be used were washed with distilled water to remove debris and after which, air dried for two weeks. The dried leaves were crushed using pre-washed and sterilized mortar and pistol into powdery form. 5 g, 8 g and 10 g of the leaves, roots and stembark respectively were weighed into sterile conical flasks differently. 100 ml of each of the extraction solvents were added to the weighed powders, shaken vigorously for some time and allowed to stand undisturbed for 72 hours. After 72 hours, the extracts were separated using Whatman No 1 filter paper into sterile beakers; the recovered liquid extracts were evaporated till they were aqueous and preserved for further use. After extraction, 4.3 g, 8 g and 6.5 g of the leaves, stembark and root aqueous extracts were obtained respectively.
Screening of Extracts for Antimicrobial Actions Using Agar Well Diffusion Method
From a 24 hour old broth culture of each organism, 0.1 ml was seeded on prepared Mueller Hinton agar plates, spread evenly using a glass rod spreader and allowed to stand for 2 minutes. Using a 9 mm sterile cork borer, four wells were bored on the plate and 0.1 ml of the test extracts were dispensed into each well; the extraction solvents were used as control and put into the fourth well. The plates were allowed to stand for 30 minutes and thereafter incubated at 37 °C for 24 hours. This procedure was repeated for each of the isolates. After 24 hours, the plates were examined for zones of inhibition determined by measuring the area where the growth of the organism was inhibited.
Screening of Extracts for Antimicrobial Actions Using Disc Diffusion Method
Isolates were suspended in distilled water and adjusted to 0.5 Macfarland’s standard which is equivalent to about 108 Cfu/ml 15. 0.1 ml of the suspension was seeded on prepared Muller Hinton agar, spread using a sterile glass rod spreader and allowed to stand for 2 minutes. Filter papers were cut into small pieces of 9 mm, sterilized in a hot air oven at 200 °C for an hour and then impregnated with the extracts. The impregnated filter papers were then placed on the inoculated plates aseptically. Four impregnated filter papers were placed on each plate. The fourth disc was impregnated with the extraction solvent. The set up was allowed to stand for 30 minutes and thereafter incubated at 37 °C for 24 hours. After 24 hours, the zones of inhibition was measured and recorded in millimeters.
Determination of Minimum Bactericidal Concentration (MBC) and Minimum Inhibitory Concentration (MIC)
Four test tubes were set up for each extract to which 9 ml of the nutrient broth was added, the mouth plugged with a cotton wool and sterilized at 121 °C for 15 minutes. After cooling, into the first tube labeled 10-1, 1 ml of the test extract was added and then it was serially diluted to 10-4. This process was repeated for the other extracts. 0.1 ml of a 24 hour old broth culture of the test organism was then introduced into each of the tubes having varying concentrations of the test extract, shaken thoroughly and incubated at 37 °C for 24 hours. Positive controls had 9ml of nutrient broth and the organism alone while negative control had 9 ml of nutrient broth and the test extract alone. The test tube showing no visible growth (growth is evidenced by turbidity) was taken as the minimum inhibitory concentration (MIC).
To determine the MBC, 0.1 ml from the different MIC tubes was inoculated on nutrient agar plates and spread evenly using a sterile glass rod. The plates were incubated at 37 °C for 24 hours and the plates with no growth were taken as the minimum bactericidal concentration (MBC).
Results
Ethanol, distilled water and methylated spirit were used as solvents in obtaining the leaf, root and stembark extracts of Allanblackia floribunda. The antimicrobial activity of the extracts was thereafter tested against four pathogenic isolates. Table 1 shows the activity of the various extracts on the test isolates. From the table, all three parts of the ethanol extract showed activity against S. aureus and Bacillus sp. while none of the distilled water extracts showed activity against the isolates. Ethanol extract of the bark showed no activity against Pseudomonas sp. and Escherichia coli but the other parts showed activity against them. (Figure 1) Methylated spirit extracts however showed varied activity against the isolates. Table 2 shows that at a concentration of 10-1, ethanol extract of the three parts inhibited the growth of the isolates while at a concentration of 10-3 none of the extracts were effective against the isolates. Table 3 shows that the methylated spirit extracts were only active at a concentration of 10-1 while lower concentrations were ineffective. Table 4 shows the minimum bactericidal concentration of the extracts.
Table 1. Minimum inhibitory concentration of the different extracts| Isolate | Ethanol extract | Methylated spirit extract | Distilled water extract | ||||||
| L | B | R | L | B | R | L | B | R | |
| Staphylococcus aureus | + | +++ | ++ | - | +++ | +++ | - | - | - |
| Pseudomonas sp. | +++ | - | + | - | - | ++ | - | - | - |
| Escherichia coli | +++ | - | +++ | - | - | - | - | - | - |
| Bacillus sp. | + | +++ | + | + | + | ++ | - | - | - |
Figure 1.Zones of inhibition of the extracts on Escherichia coli (hole 3 with distiled water as control shows no zone of inhibition)
| Isolate | Leaves | Bark | Root | |||||||||
| 10-1 | 10-2 | 10-3 | 10-4 | 10-1 | 10-2 | 10-3 | 10-4 | 10-1 | 10-2 | 10-3 | 10-4 | |
| Staphylococcus aureus | + | - | - | - | + | + | - | - | + | - | - | - |
| Pseudomonas sp. | + | + | - | - | + | - | - | - | + | - | - | - |
| Escherichia coli | + | - | - | - | + | + | - | - | + | - | - | - |
| Bacillus sp. | + | + | - | - | + | - | - | - | + | - | - | - |
| Isolate | Leaves | Bark | Root | |||||||||
| 10-1 | 10-2 | 10-3 | 10-4 | 10-1 | 10-2 | 10-3 | 10-4 | 10-1 | 10-2 | 10-3 | 10-4 | |
| Staphylococcus aureus | + | - | - | - | + | - | - | - | + | - | - | - |
| Pseudomonas sp. | + | - | - | - | + | - | - | - | + | - | - | - |
| Escherichia coli | + | - | - | - | + | - | - | - | + | - | - | - |
| Bacillus sp. | + | - | - | - | + | - | - | - | + | - | - | - |
| Isolate | Ethanol extract | Methylated spirit | ||||
| L | B | R | L | B | R | |
| Staphylococcus aureus | 10-1 | 10-2 | 10-1 | 10-1 | 10-1 | 10-1 |
| Pseudomonas sp. | 10-2 | 10-1 | 10-1 | 10-1 | 10-1 | 10-1 |
| Escherichia coli | 10-1 | 10-2 | 10-1 | 10-1 | 10-1 | 10-1 |
| Bacillus sp. | 10-2 | 10-1 | 10-1 | 10-1 | 10-1 | 10-1 |
Discussion
The incidences of antimicrobial and especially antibacterial resistance outcome globally, have been on the increase even with the production of improved antimicrobial agents with broad spectrum insights and capacities. This has led to constant presence and high prevalence of infectious diseases, especially in the remote villages with visible lack of functional health care facilities, to manage the sick and possibly the increasing trends of epidemic outbreaks. Sequel to this, there is continuous search for novel drugs with better antimicrobial activities especially among plants that should be effective and at the same time environmental friendly. The potency of drugs from natural sources such as plants stems from the presence of bioactive substances in the plants. However, there is therefore a gradual shift from the use of synthetic drugs to formulated drugs from natural sources as therapeutic agents. This study thus tested the efficacy of parts of Allanblackia floribunda on four pathogenic bacteria.
The leaves of plants such as bitter leaf, scent leaf, Bryophyllumpinnatum and Aspiliaafricana have been studied and found to be active against microorganisms such as S. aureus, Pseudomonas aureus, Escherichia coli and Bacillus sp. 11, 16. Some strains of S. aureus have been exhibiting resistance to antibiotics such as methicillin which has been the drug of choice in the treatment of Staphylococcal infections. Although studies on the antimicrobial effect of Allanblackia floribunda on bacterial isolates are scarce, nonetheless, extracts of ginger, mushroom, garlic and other plants have been tested on some bacteria of medical importance 17.
However, in a study carried out by Udi-Ibiam, hot and cold water extracts of mushroom, ginger and garlic tested against S. pyogenes, P. aeruginosa, E. coli, S. aureus and Salmonella typhi demonstrated antimicrobial activity against all the test isolates except E. coli. In this present study, the distilled water extract of all the three parts of the leaves were inactive against the test isolates. This is in consonance with a previous study 16 where hot water extracts of Bryophyllumpinnatumand Aspiliaafricanashowed no activity against Staphylococcus aureus, Escherichia coli and Pseudomonas aeruginosa from wound samples. Cold water extract of the fresh leaves of Moringa have however demonstrated activity against S. shinga, P. aeruginosa, S. sonnei, Pseudomonas spp. and S. aureus, B. cereus, Streptococcus hemolytica, B. subtilis, S. lutea and B. megaterium while the ethanol extract of its fresh leaves exhibited a high antibacterial activity compared with the former 18.
The ethanol extract from the leaves and roots demonstrated strong antimicrobial activity against all four test isolates. The ethanol extract of the plant bark showed zero activity against P. aeruginosa and E. coli. In a related study, the ethanol extracts of Bryophyllumpinnatumand Aspiliaafricana were active against Staphylococcus aureus, Escherichia coli and Pseudomonas aeruginosa 16. Also, in a similar study by Azuonwu et al.19, methanolic extract of the bark of Moringaoleifera showed activity against Escherichia coli. However, in another study by Babota et al., both the methanolic and ethanolic extracts of Helichrysumarenarium and Antennariadioica demonstrated antimicrobial activity against S. aureus, Escherichia coli and Bacillus cereus 20.
Methylated spirit extracts of the plant root demonstrated activity against all isolates except E. coli; the methylated spirit extract of the bark also demonstrated activity against S. aureus and Bacillus sp. while the leaf extract from methylated spirit only demonstrated activity against Bacillus sp. These further prove the fact that for every sample to be extracted and tested for its antimicrobial activity, the solvent for extraction could probably play a huge roll towards determining the efficacy and overall potency of the extract.
More often, S. aureus isolated from hospitals are resistant to several antibiotics 11. The ability of S. aureus to cause septicemia, pneumonia and even bone and joint infections makes it a microorganism of clinical importance. Also, over time, P. aeruginosa has been known as an opportunistic pathogen as it has been seen as a major cause of pneumonia, nosocomial infections, urinary tract infections (UTIs) and subsequently drug resistance outcome 21. E. coli on the other hand has been largely implicated in UTIs as well as gastrointestinal infections. Bacillus sp. has been a major cause of bacteremia, endocarditis, pneumonia and further still one of its species has been implicated in food poisoning outbreaks in our communities. These infections caused by these microorganisms thus, make it necessary that alternative drugs that exhibit high therapeutic index activity against them be developed, even with much devoted interest focused towards the non-environmental distortive capabilities from the end products or residues of such drugs. The ability of these extracts to act against these microorganisms selectively is thus, very critical; this novel strategy and effective drug discovery outcome, should be sustained and encouraged globally as an alternative approach towards tackling the increasing trend of muti-drug resistance issues in our communities/health facilities across the globe.
Conclusion
The root, bark and leaves of Allanblackia floribunda demonstrated antibacterial activity against Staphylococcusaureus, Escherichiacoli, Bacillus sp and Pseudomonas sp. The results obtained from this study to a reasonable extent, supports claims that this plant parts can be used in the treatment of animal and human diseases. The effectiveness of the plant in vivo was not determined; therefore further studies on this can be carried out to determine its effectiveness in vivo as well as the safe dosage in practical terms. This will help determine the effective dosage with no side effects. The more efficient and robust extraction methods other than maceration are very expensive to acquire, hence this has enhanced their reduced use to improve health of the subjects through the production of these medicinal plants in large quantities. However, it will be plausible if this equipment will be made available for further research to determine the best method for the extraction of bioactive substances from natural sources without denaturing them and not polluting the ecosystem in the same vain.
Acknowledgement
We are ever grateful to Prof. S.D Abbey and Prof G.N Wokem for their continuous support and source of inspiration. Also we are thankful to all the laboratory staff of the University of Port Harcourt Teaching Hospital for their technical support; even as we will not fail to mention the exceptional support of Azuonwu, Testimonies Chikanka for typesetting and correction of the observed errors.
References
- 1.Verpoorte R C. (1998) Hemo diversity and the biological role of Secondary metabolites, some thoughts for selecting plant material for drug development. , ProcPhytochem Soc, Europe, Kluwer Publishers 343, 11-24.
- 3.Neethu S K, Neethu S. (2016) Invitro Antimicrobial Activity And Phytochemical Analysis Of Muraya koenigii (L) Leaf Extracts. , Global Journal of Science Frontier Research: Biological Science 16(1), 1.
- 5.Azuonwu T C, Aina D A, FOI Odutayo, Majolagbe O N, Ezeamagu C O et al. (2017) Comparative studies of production of exopolysaccharides from wild type, mutants and hybrid of Pleurotus pulmonarius and Pleurotus ostreatus in submerged culture. , acta SATECH 9(1), 121-127.
- 6.Raj B A, Murugamani V, Madhuri B. (2011) Preliminary phytochemical investigation of Givotia moluccana Stem. , Int J Res Pharm Biomed Sci 2(3), 1307-1313.
- 7.Silva O A, Duarte J, Cabrita M, Pimentel A, Diniz G E. (1996) Antimicrobial activity of Guinea-Bissau traditional remedies. , Journal Ethnopharmacology 50, 55-59.
- 8.Iram G, Mariam S, Halima S, Shahbaz M A, Amin M A. (2012) Effect of garlic and ginger including aqueous extract, methanol extract and ethanol extract had been assayed separately against drug resistant strains. , Annuals of Clinical Microbiology and Antimicrobials 11(8), 11-18.
- 9.Mboto C I, Eja M E, Adegoke A A, Iwatt G D, Asikong B E et al. (2009) Evidence of accelerated healing of male circumcision wounds, fresh wounds and chronic ulcers using combined therapy of Garcinia kola, Vernonia amygdalina extracts in honey. , African Journal of Microbiology Research 3(9), 557-559.
- 10.Akinjogunla O J, Ekoi O, Odeyemi A T. (2011) Phytochemical screening and in-vitro antibacterial assessment of aqueous leaf extracts of Vernonia amygdalina (Asteraceae) and Ocimum gratissimum (Lamiaceae) on moxifloxacin resistant Escherichia coli isolated from clinical and environmental samples. , Nature and Science 9(7), 12-16.
- 11.Oshim I O, Desmond C O, RAU Nwobu, Ezugwu U M, Urama E U. (2016) Bactericidal Concentration and Minimum Fungicidal Concentration of Vernonia amygdalina (Bitter leaf) on Microorganisms Isolated from Wound Infections. , International Journal of Surgical Research 5(1), 8-14.
- 12.Bürkle E, Palenberg M. (2009) Allanblackia Supply chain as a Strategic Alliance with Unilever R&D Netherlands. Global Public Policy Institute,GPPi.19-20.
- 13.Buss C, Tissari J. (2010) Allanblackia- an ingredient for poverty reduction www.rural21.com/uploads/media/R21_Allanblackia_0310_01.pdf visited onJuly12,2018.
- 14.Orwa C, Mutua A, Kindt R, Jamnadass R, Simons A. (2009) Agroforest tree Database: a tree reference and selection guide version 4.0 (http://www.worldagroforestry.org/af/treedb/).
- 15.Cheesbrough M. (2006) District laboratory Practice in Tropical Countries. Part 2.CambridgeUniversityPress. 143-157.
- 16.Azuonwu O, Azuonwu T C, Ibulubo D. (2017) Antimicrobial Activity of Leave Extracts of Bryophyllum pinnatum and Aspilia africana on Pathogenic Wound Isolates Recovered from Patients Admitted inUniversity of Port Harcourt Teaching Hospital. , Nigeria, Ann Clin Lab Res 5(3), 185.
- 17.Udu-Ibiam O E, Ogbu O, Nworie O, Ibiam U A, Agah M V et al. (2014) Antimicrobial Activities Of Some Selected Edible Mushrooms And Spices Against Clinical Isolates From Federal University Teaching Hospital Abakaliki (FETHA). , Ebonyi State, Nigeria, International Journal of Scientific & Technology Research 3(5).
- 18.Rahman M M, MMI Sheikh, Sharmin S I, Islam M S, Rahman M A et al. (2009) Antibacterial Activity of Leaf Juice and Extracts of Moringa oleifera Lam. against Some Human Pathogenic Bacteria CMU. , J. Nat. Sci 8(2).
- 19.Azuonwu T C, FOI Odutayo, Aina D A. (2015) . , Antibacterial Activities of Moringa Oleifera Plant Bark, Leaf, and Seed Extracts on Abattoir Waste Water. Academic Journal of Life Sciences 1(2), 31-34.
